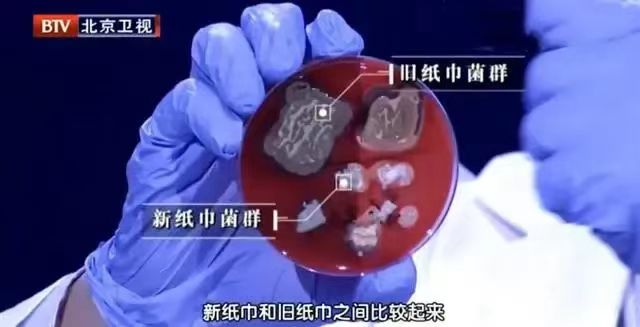

朱颜辞镜推荐:生活小窍门
朱颜辞镜推荐 | 再出去旅游,你就这么拍,普通场景变摄影大片
来源: 摄影自学班 2023-09-15 侵删
对于旅游摄影,有一些技巧,可以帮助您将普通的场景拍摄成大片。6句旅游摄影口诀,帮你拍美旅游风景照片!有道是:鲜艳颜色暗背景。用上点缀没毛病。遇到水面拍倒影。仰拍大树必须行。离远离近环境定。清晨傍晚不要停。
图1:
一、鲜艳颜色暗背景。
在拍摄风景时,可以选择鲜艳的颜色作为主体,并使用暗背景进行衬托。这样可以突出主体的色彩,让画面更加生动。如果背景过亮或过杂乱,可以使用虚化技巧,将背景变得模糊,从而让主体更加突出。怎么让背景变得更暗呢?
图2:
手机拍摄时,对焦后,在对焦框旁有个按钮,按住,往下拖拽,就是降低曝光,整体就暗了,但因为主体有被光照到,所以,主体受到的影响并不大,就能拍出图1和图2这样效果了。
二、用上点缀没毛病。
图3:
在拍摄风景时,可以加入一些点缀元素,例如花朵、石头、蝴蝶等,这些元素可以让画面更加生动有趣。同时,也可以利用点缀元素的形状、色彩等与主体相互辉映,增强画面的表现力。利用点缀,要就地取材,不要局限,比如图3,从下往上仰拍树木时,用落叶作为点缀,丰富了前景内容,还让照片显得更加立体。
三、遇到水面拍倒影。
图4:
当我们遇到水面时,可以尝试拍摄倒影。通过将手机镜头稍微倾斜,可以将周围的景色倒映在水面上,形成一幅美丽的画面。同时,可以利用倒影的形状、色彩等来构图,让画面更加富有层次感和变化。图4,不只是倒影,更主要的是,整体色彩少,画面不简约。
图5:
图5是只保留水面倒影,让照片像艺术作品一样。图6是平常的倒影,但画面中有明暗对比,所以不单调。
图6:
四、仰拍大树必须行。
在拍摄风景时,可以选择仰拍大树的方式,这样可以呈现出大树的高大和壮观。同时,可以利用大树的树叶、树枝等来构图,让画面更加富有变化和层次感。图7,伸向天空的大树,让画面看起来更有穿透力。
图7:
五、离远离近环境定。
在拍摄风景时,可以根据实际情况选择离远或走近拍摄。当我们需要拍摄大场景时,可以选择离远拍摄,这样可以呈现出景色的全貌和广袤,像图8这样;当我们需要拍摄细节时,可以选择走近拍摄,这样可以呈现出景色的细节和质感,像图9这样。但具体拍大景还是小景,取决于现场是否乱套。
图8:
比如图8,画面中没有其他捣乱的景物,所以拍得辽阔一点,照片也可以很干净。图9,现场元素比较多,所以不得不缩小取景范围,突出一棵大树。
图9:
六、清晨傍晚不要停。
图10:
在拍摄风景时,清晨和傍晚是最佳时间。此时的光线柔和、色彩丰富,可以让画面更加生动和富有变化,像图10和图11,都是在傍晚时候拍摄的。所以,在旅游时,应该合理安排时间,不要错过这两个时间段。同时,可以在日出和日落时使用三脚架等辅助设备,以保证画面的稳定性和清晰度。
图11:
这6句摄影口诀,利用起来吧!

朱颜辞镜推荐 | 面包可以冷藏吗?
来源:健康中国 侵删




布谷鸟推荐 | 幸亏被提醒:洗衣机「快洗」不能随便用,原来我一直用错了
来源: 新住 2023-10-06 侵删
家居、生活中,有很多我们习以为常的做法,其实一直都是错的。
这期,我就来分享10个我们做错的事情,相信看完会让你有醍醐灌顶的感受。
1、快洗不能随便用
我们家就有一个急性子,但凡洗衣服,就用快洗。
可,这种做法是错的!完全不可取的!
因为快洗本质上,是通过3个策略,来提升洗涤速度的:
①减少洗涤水量,从而提升进水和排水速度。可如此,也就注定快洗的局限,只能放一半衣服。否则就洗不干净;
②减少漂洗次数,来提升速断,也就意味着它的漂洗并不算干净;
③提高转速,也就意味着,磨损会变大。纯棉都能被洗坏。
所以,其实快洗只适合着急穿衣服,而且只有一两件,衣服面料还正好是抗造的情况下。
2、出门两小时不用关空调
原本以为,不热了、临时出门关空调是个好习惯,能节省电,所以一直我都是这么干的。
直到,有一次我看到了一个名为:“出门两小时需要关空调吗”的投票。

我才去做功课看了很多厂家的指导,才发现我一直做错了。
原来短暂出门关空调,之后回家,再重启,对于现在的空调,重启所用的电,比两小时不关用的电还要多。
甚至,有顶尖的空调品牌,还声称,6小时之内要重启,都不必关空调,想省电只要把温度调高一点即可。
3、洁厕灵要涂完等会再刷
用洁厕灵,谁不会用,无非就是把洁厕灵涂到马桶上,然后再刷掉即可。
可实际上,这样做并不完全对。
 中间,还需加一个步骤,倒入洁厕量之后,要静置五分钟,才能更好的让洁厕量与污垢发生反应,从而达到事半功倍的效果。
中间,还需加一个步骤,倒入洁厕量之后,要静置五分钟,才能更好的让洁厕量与污垢发生反应,从而达到事半功倍的效果。
了解了这个事情之后,我才知道,为啥总感觉自己家的洁厕灵效果不太行。

其实洁厕量是典型的酸性清洁剂,不仅对马桶有效,对陶瓷盆、对玻璃上的水垢也有效,除水垢也是一绝。
4、酒店拖鞋是套着穿的
酒店一般都会有凉拖鞋和一次性拖鞋两种选择。
以前一直以为一个是冲澡穿的,一个是在酒店里行走穿的,所以一直很别扭,因为穿一次性拖鞋不舒服,直接穿凉拖鞋又害怕别人的脚气。
 可其实,酒店拖鞋的正确穿法,应该是两种组合。
可其实,酒店拖鞋的正确穿法,应该是两种组合。
冲澡,完全可以不穿拖鞋,因为酒店的浴室防滑都做得很好;
在酒店内行走,则可以一次性拖鞋当作凉拖鞋的内衬,舒服又卫生。
5、双肩包背面可以挂东西
双肩包,咱每个人都经历过好几个:
肯定有经历过这种带挂绳的款式;

我就经历过,但从来没用过,只是以为它就是个单纯的装饰。
 可实际上,这个挂绳功能那就多了,从球鞋、衣服、到羽毛球拍、篮球……几乎所有要随手拿的东西,都可以用这个挂绳去固定。
可实际上,这个挂绳功能那就多了,从球鞋、衣服、到羽毛球拍、篮球……几乎所有要随手拿的东西,都可以用这个挂绳去固定。
也肯定有经历过,这种带“小猪鼻子”标签的背包;

憨憨的我,长到30岁,还以为这是某种标志。
可实际上,人家猪鼻子中间的那根带子,是一个挂环,可以用来挂帽子、挂球鞋、挂钥匙……
6、发带反着戴可以扎头发
这种带长耳朵的发带,作为直男,我唯一能有的理解,就是女生觉得可爱,为她买单的。

可实际上,有很大一部分长耳朵发带,耳朵里是有跟铁丝的。
 其除了让女生变得可爱外,还是个头发固定器,只要把它反着戴即可。
其除了让女生变得可爱外,还是个头发固定器,只要把它反着戴即可。
7、马桶垫纸光面贴马桶,不用撕中间部分
一次性马桶垫,在外面咱用的机会不少,从来都觉得这东西,又爱滑落、又麻烦,还得专门取下来冲走,可实际上是我们没用对。

一次性马桶垫正反两面,是不同的材质;
正面是砂面的,反面是光面的,用的时候,应该是砂面贴着皮肤,光面贴着马桶。
因为光面有一层蜡质,在人的温度作用下,可以贴在马桶上,不容易滑落。
 而且,也不用把中间那个纸撕掉。
而且,也不用把中间那个纸撕掉。
这个纸有两个作用,其一是防溅水;其二是方便冲走。
冲马桶时,中间的纸,会带着整个马桶垫,一起被冲进下水道。
8、保温杯盖可以挂杯子上
如果不知道保温杯盖密封圈上还有个小舌头设计的人。
恐怕会一直误会保温杯盖,做成圆的,扣着放会不干净,倒着放又放不稳。
 但实际上,人家杯盖能设计成圆的,就已经考虑过这个问题了,一般都会在密封圈上设计一个小舌头。
但实际上,人家杯盖能设计成圆的,就已经考虑过这个问题了,一般都会在密封圈上设计一个小舌头。

其作用就是用来挂杯盖的,干净、卫生、不怕倒,还不怕忘记杯盖在哪里。
9、奶茶上的小盖子
作为奶茶爱好者,相信大多数人,都对杯子上的小盖子有所了解。

其作用是某些奶茶有奶盖,这个小盖子打开,方便喝奶盖。
但实际这个小盖子可不止这一个功能。

它还有另外一个作用,是用来堵吸管的,防止脏东西从吸管进入杯子。
可如果用来堵吸管,喝奶盖的口,就封不住了,照样会掉脏东西进去?
这就要说到你常见的,店员给你现场扣上去的场景了,其实本来可以在工厂完成,提升效率,可为何偏偏要在现场扣,其目的就是给你一次多拿一个小盖子的机会。
10、伸缩酸奶吸管可以卡住
伸缩的酸奶吸管,确实是方便了,可也会有不小心压下去,导致吸管进酸奶盒的尴尬场景。
以前的我,还吐槽过这一设计,后来,被人无情的点醒。

原来人家做这种伸缩吸管的早都考虑过了,都在吸管凹进去的圆环内有一个小设计。
或者转一下,或者往外拉一下,吸管就可以卡住了,完全不用担心,吸管掉进酸奶盒里。
写在最后
所以,生活处处有学问,这句话并不假。
有时候,稍微做一点学问,会让我们的生活变得更便利,这也是新住价值所在,我们日后定会加倍努力,去消除这种家居、生活上的居住差。
布谷鸟推荐 | 活了三十年才知道,原来卫衣上的绳子是这样系的
布谷鸟推荐 | 9块9一箱的卫生纸,到底脏不脏
来源:新周刊 2023-09-21 侵删
作为日常生活必备,卫生纸的价格受到很多人的关注。
面对超市里动辄十几块,甚至几十块一包的卫生纸,不少消费者将目光投向了网上购物平台,并发现了不少价格十分优惠的卫生纸,只要几毛或者一两块一包,9块9一箱的也不在少数。
 随着木浆原材料价格的上涨,纸巾也变得越来越贵。(图/图虫创意)
随着木浆原材料价格的上涨,纸巾也变得越来越贵。(图/图虫创意)
对此,却有不少博主指出,如此便宜的卫生纸可能有“毒”,用不得。
那么,9块9一箱的卫生纸到底怎么样?如果不用来擦嘴,只擦屁股行不行?
 9块9的“毒”纸巾?
9块9的“毒”纸巾?
讲“毒”纸巾之前,我们先了解点基本知识:纸巾和卫生纸不是同一个东西。
按照国家最新标准,纸巾指的是面巾纸、餐巾纸以及手帕纸,执行的是国家纸巾标准GB/T 20808-2022,而卫生纸则指的是厕所用纸,执行的是国家卫生纸标准GB/T 20810-2018。这意味着,纸巾和卫生纸的制作要求和菌落要求就不一样。
在原材料的选择上,纸巾应使用木材、草类、竹子等制成的原生浆(草浆、木浆、竹浆等),不应使用任何回收纸、纸张印刷品、纸制品及其他回收纤维状物质作原料,不应使用脱墨剂。而卫生纸的生产可以用原生浆,也可以用添加回收纸做的回用浆。
在菌落要求上,卫生纸的标准也要比纸巾低上不少。具体来看,卫生纸的细菌含量应≤600菌落总数/克,真菌菌落总数没有规定;纸巾的细菌含量应≤200菌落总数/克,真菌菌落总数≤100菌落总数/克。
另外,卫生纸对于是否有迁移性荧光增白剂的含量没有要求,纸巾则要求不能含有荧光增白剂。
 纸巾性能要求部分表(图/国家标准截图)
纸巾性能要求部分表(图/国家标准截图)
 原生浆(纤维)卫生纸和卫生纸原纸技术指标部分内容(图/国家标准截图)
原生浆(纤维)卫生纸和卫生纸原纸技术指标部分内容(图/国家标准截图)
但在实际情况中,对于某些本就在生产不合规产品的厂家来说,纸巾和卫生纸都差别不大,为控制生产成本,他们所用的原材料多是回收来的处理不完全的生活垃圾,比如废纸、碎布、烂纱布……即使发霉发烂发臭,也不要紧。
为了提高纸巾/卫生纸的柔软性,部分企业甚至会加入工业滑石粉。为了让废料制作的纸巾/卫生纸更好看更白,商家还会在里面加入大量的荧光增白剂。
除了用料“毒”,这些产品的制作过程也让人无法直视。
在正常情况下,纸巾生产厂要保证生产区域及其周围的环境整洁,生产车间内要配置质检设备,工作人员更是需要穿工作服、戴手套、戴口罩。
然而,在央视《每周质量报告》节目的镜头下,某些纸巾作坊的制造场地里,到处都是灰尘、纸屑和回收的废纸原料,工作人员也并未穿相应的工作服、未戴手套及口罩。
如此生产制造出来的产品,也难怪商家能在超低价的情况下还有利润空间。
 脏乱的纸巾生产环境。(图/《每周质量报告》截图)
脏乱的纸巾生产环境。(图/《每周质量报告》截图)
 “毒”纸巾能用吗?
“毒”纸巾能用吗?
那么,不用这些“毒”纸巾擦嘴,只拿来擦手、擦桌子行不行?
建议是,最好别用。
就实际使用情况来看,对于部分体质较弱的群体来说,用一两次就可能出现不适。央视网《每周质量报告》生活用纸专题调查也表示,即使是体质健康的人群,若长期使用“毒”纸巾,也很可能出现健康问题。
 长期使用“毒”纸巾,可能会带来健康问题。(图/图虫创意)
长期使用“毒”纸巾,可能会带来健康问题。(图/图虫创意)
“毒”纸巾带毒的关键就在于它自身比正常的纸巾/卫生纸多了些“有毒物质”。《每周质量报告》中质检局的检验结果表明,“毒”纸巾上存在过量的细菌菌落,可能会对人体皮肤造成直接伤害。其中若存在的大肠杆菌、幽门螺杆菌、痢疾杆菌等病菌,进入体内还会引发肠炎、伤寒、痢疾等病,甚至可能导致使用者患上肝炎。
另外,“毒”纸巾中含有的过量荧光增白剂、滑石粉、漂白剂和甲醛等物质,单拎一个出来都有着极大“威力”。在使用过程中,这些有害物质会通过接触人的皮肤从而进入人的体内产生危害。比如,荧光增白剂含化合物苯,长期与皮肤接触可能引发白血病。滑石粉本身含有多种重金属,进入体内不易排出,会损害人体神经系统和血液系统,还会导致儿童发育迟缓和智力低下。
 “毒”纸巾可能含有过量增白剂。(图/央视新闻截图)
“毒”纸巾可能含有过量增白剂。(图/央视新闻截图)
另外,千万别存“便宜卫生纸只擦屁股就没啥大问题”的侥幸心理。
一是这些卫生纸可能容易破、透手,二来肛门的皮肤也很脆弱,遇上大量有害细菌也容易感染。特别是对于女性来说,长期使用这些“毒”卫生纸,还可能得一些妇科疾病。
再有人说,那我放厨房用,总没问题了吧。试想一下,当你左擦擦右擦擦时,不计其数的有害物质粘在炒菜、吃饭的器具上……
 用纸错误也致毒?
用纸错误也致毒?
有时候,就算我们买的不是“毒”纸巾,如果使用方法不当,也有可能对自己造成伤害。
比较常见的是使用开封太久的纸巾/卫生纸。北京卫视《我是大医生》节目曾对开封了48小时的旧纸巾和新纸巾进行了对比检测,结果发现,旧纸巾菌群比新纸巾多了不止一倍。而且旧纸巾存在大量的杆菌,是肠道内常见的寄生菌。如果体质较弱的人群长期使用这种纸张,可能会引起感染性疾病,出现腹泻、呕吐、发烧等症状。
再比如使用过期的纸巾/卫生纸。一般纸巾的保质期是3年,超过保质期的纸巾细菌可能会超标,也会对身体有害。
咱就是说,虽然卫生间里堆积着足够的卫生纸,能给人满满的“安腚”感,但还是别一下囤太多。
新旧纸巾的菌群对比。(图/北京卫视《我是大医生》截图)
新旧纸巾的菌群对比。(图/北京卫视《我是大医生》截图)
值得注意的是,最好也不要混用擦嘴和擦屁股的纸。
由前文提到的国家标准来看,两者的菌落要求标准就差了好几倍,用擦屁股的纸擦嘴可能会增加细菌感染的风险,而用擦嘴的纸擦屁股很容易堵厕所,因为其湿韧强度往往高过擦屁股的纸,不易泡烂。
万一最后还得找人通马桶,花的可能就不止一包纸的钱了……
 纸巾该怎么选?
纸巾该怎么选?
不过,直接把9块9一箱的纸巾/卫生纸归为有“毒”也有点武断和片面,它的便宜也可能另有隐情。
偷工减料就是其中一种。很多9块9一箱的抽纸尺寸都很小,买家秀里展示的抽纸也是看起来又大又厚实,结果买回来才发现一张纸还没巴掌大,而且没用几次就完了。还有些商家在纸张厚度上下功夫,别人四层,它只给两层,整体算下来,量少了一半,价格自然也不会太高。
 和这一情况有异曲同工之妙(图/小红书截图)
和这一情况有异曲同工之妙(图/小红书截图)
另外,卖纸巾和卫生纸也属于直播间的经典营销模式。低价产品只是利薄,如果销量提上来,总体利润依然十分可观。
几块、几毛钱的纸巾和卫生纸还可以作为直播间的引流产品/福利产品。这样的产品能够狠狠抓住消费者“薅羊毛”的心理,吸引大批观众来到直播间,届时再乘机卖出其它产品。
那么,在日常生活中,怎样才能快速简单地辨别出安全卫生的纸巾/卫生纸?
比价格,不买明显低于市场价格的纸巾/卫生纸,当然,大品牌搞促销满减除外。
闻气味,如果有类似化学药剂的味道或其它刺鼻味道,不要用。
试着搓、扯纸巾/卫生纸,不掉毛、掉粉少,且不会轻易断裂,则质量较好。
看包装,一比原料,100%原生木浆最好,其次是原生浆、纯木浆(木料为主要原料,但是很可能包含废纸浆、再生浆等回收再利用的原料)、混合浆(部分回收浆+部分原生浆);二比档次,纸巾是优等品>合格品,而卫生纸是优等品>一等品>合格品。
总的来说就一句话,买便宜纸巾和卫生纸时,一定要擦亮双眼!
甜心推荐 | 鲜花养护:绿毛球收花醒花及养护
来源:斗南云舍花卉 2023-09-07 侵删
除了种植花草,越来越多的人也因网络购物的便捷,而爱上了在云南等鲜花种植基地购买鲜花回家插瓶。如何才能让这些花更好地绽放?花期更长?这成了不少爱花之人的困扰问题。
解决这些问题最关键的一步就是:在家里收到花以后,先不要直接插瓶,第一步先醒花、醒花、醒花 ,大多网购鲜花都是从云南等鲜花基地采摘后直发,发货都是新鲜的状态。但长途运输途中还是会缺水,所以收到后一定要深水醒花,快速补充水分,这样才能更好地绽放,花期也更长,多了解一些养护知识,认真养护,静待花开吧!
今天就以这款“绿毛球”为例,来跟大家聊聊鲜花插瓶养护的话题。
花材养护 T绿毛球]

绿石竹(石竹科石竹属),人们通常叫它绿毛球或绿毛康,毛茸茸绿色花头憨态可掬。原产于欧洲,绿色,是一种耐寒耐热耐干的植物,有着顽强的生命力和不轻易屈服的精神。
毛茸茸的头部就像一个小绿球,每一个小球的直径根据不同等级呈2-6厘米。她的身材纤细,和头部比起来显得太过于苗条,就好比动画片里的“大头儿子”绿色总能给人一种回归大自然原生态的享受,用绿石竹球搭配的花束显得十分宁静,活力满园。
绿毛球的花语为纯洁的爱、才能、大胆、女性美

绿毛球如何养护?
01收花醒花:
收到花以后先不要直接插瓶,第一步先醒花
深水醒花环节
1.绿石竹经过运输后,通常花头被挤压得比较严重这是正常现象,吃水后就会变得蓬松饱满。
2.根部斜剪新的切口,注意不要剪到关节处,吸水不好,然后放醒花桶深水醒花4-6小时,水位要高,花苟以下都泡水里。

02 插花养护:
1.醒花完成后,去除有伤或萎蔫的花叶,绿石竹的叶子容易脱水变黄,醒花后应该把全部的叶子去掉,最多只保留顶端几片。
2.绿毛球浅水位养护就好,大概花瓶3分之1水位即可,水中加入保鲜剂,有保鲜剂可以2-3天换水一次,换水注意剪根,清洗花瓶和花材根茎。
3.用螺旋的手法插瓶,能有效避免花材摩擦,瓶口留足够的空间,保证空气畅通。
4.绿毛球和其他花材搭配插花,更有感觉,可以自行搭配,避免阳光直晒,不要放在空调出风口。

注意事项
1.绿毛球处理叶子要环剥叶片,不要竖着撕,很容易把花杆弄坏,影响花期。
2.其实我们看到的绿毛球观赏的是它的花萼,它养护一段时间会开花。





